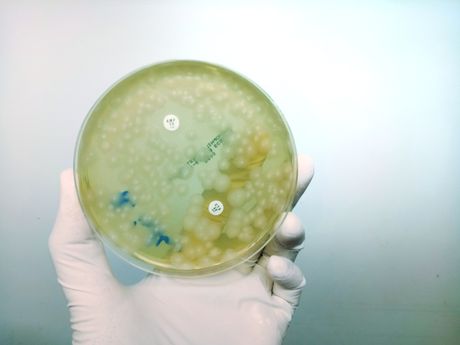
laboratorija, bakterija

Opasna BAKTERIJA pronađena u proizvodu iz Srbije! Hitno povučen sa tržišta - prodavac PAPRENO kažnjen
U prehrambenom proizvodu koji je stigao u Hrvatsku iz Srbije pronađena je štetna bakterija, te je cela pošiljka odmah povučena iz prodaje i uništena.
Reč je o proizvodu "Fino mleveni cimet", najbolje upotrebiti do 01.10.2025., broja L64124Y, pakovanom po 50 grama. Kako prenose hrvatski mediji, proizvođač je nepoznata osoba, a cimet je pakovan u Srbiji, gde je stigao iz Indonezije.
Sporni cimet prodavao je trgovinski lanac Plodine u svojim centrima u Hrvatskoj još krajem prošle godine. Inspektori su uzeli uzorak s prodajnog mesta i poslali ga na analizu u Hrvatski zavod za javno zdravstvo, gde je utvrđeno da je cimet zdravstveno neispravan.
Prema ponovljenom nalazu Hrvatskog zavoda za javno zdravstvo, utvrđena je prisustvo bakterije Bacillus cereus. Plodine su od dobavljača, firme "Yumis d.o.o." iz Niša, nabavile 10.800 komada fino mlevenog cimeta pakovanog u vrećice. Potom su ga distribuirale svojim trgovinskim centrima u Hrvatskoj.

U uzorku cimeta utvrđen je udeo Bacillusa cereusa od 4800 CFU u gramu, što je gotovo pet puta više od dozvoljene vrednosti. Državni inspektorat i Hrvatska agencija za hranu o ovom slučaju nisu izvestili javnost. Ipak, spornog začina već dugo nema u Plodinama.
Bacillus cereus
Bakterija Bacillus cereus može izazvati trovanje hranom sa simptomima koji zavise od tipa toksina koji proizvodi. Kod emetičkog tipa, koji izaziva povraćanje, javljaju se mučnina, grčevi u stomaku i povraćanje, obično 1–5 sati nakon konzumiranja zaražene hrane, a simptomi traju kratko, najčešće do 24 sata.
Diuretički tip bakterije izaziva dijareju, grčeve u stomaku i ponekad mučninu, dok je povraćanje retko; simptomi se javljaju 6–15 sati nakon unosa hrane i takođe traju oko jednog dana. Kod osoba sa oslabljenim imunološkim sistemom, poput starijih, hroničnih bolesnika ili novorođenčadi, ova bakterija može izazvati ozbiljnije infekcije van probavnog trakta, koje zahtevaju lečenje antibioticima i mogu dovesti do komplikacija.
Zbog spornog začina, Plodine su kažnjene sa 3000 evra, a odgovorna osoba u trgovinskom lancu mora da plati 300 evra. Takođe, dužni su da podmire i po 70 evra troškova postupka.
(Telegraf Biznis/Danica)
Video: Međunarodni dan reke Save obeležen edukativnim događajem "Igraj za vodu"
Telegraf Biznis zadržava sva prava nad sadržajem. Za preuzimanje sadržaja pogledajte uputstva na stranici Uslovi korišćenja.






knjigolistac
Gde ce zavrsiti te neispravne kesice? Pitanje od milion dolara.
Podelite komentar
Dunja
A koliko je takvih proizvoda koji se ne kontrolishu I iz uvoza I domacih.To je posebna prica,koliko narod oboljeva.
Podelite komentar
Marko
Kazna 3000 evra!? To više deluje kao stimulans da se tako radi i dalje..
Podelite komentar